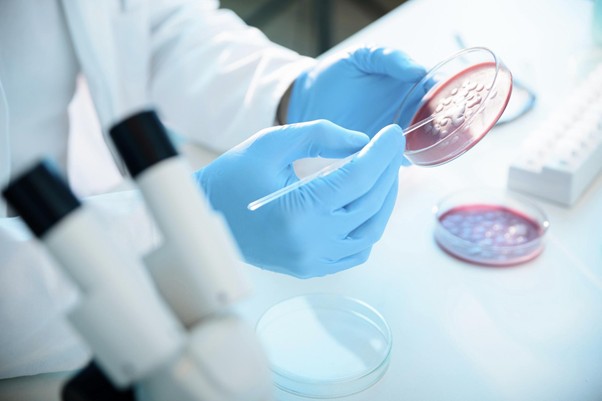

A indústria química sempre foi um setor estruturante. Energia, alimentos, habitação, mobilidade, saneamento, agricultura, mineração e praticamente todas as cadeias produtivas modernas dependem dela. Ainda assim, poucas vezes essa indústria esteve tão pressionada a se reinventar como agora.
Transição energética, descarbonização, digitalização acelerada, novas exigências regulatórias, escassez de matérias-primas críticas, volatilidade geopolítica e mudanças profundas no perfil da força de trabalho estão redesenhando o ambiente competitivo. Nesse contexto, acompanhar tendências tecnológicas deixou de ser um exercício acadêmico e tornou-se uma questão de sobrevivência estratégica.
As chamadas 10 Tecnologias Disruptivas de 2026 listadas pelo MIT Technology Review, não surgem isoladamente. Elas formam um sistema interconectado no qual energia, inteligência artificial, biotecnologia e infraestrutura digital se reforçam mutuamente. A pergunta relevante para o setor químico não é se essas tecnologias terão impacto, mas como traduzi-las em vantagem competitiva real.
1. Baterias de íons de sódio: energia como vantagem competitiva
As baterias de íons de sódio, feitas a partir de materiais abundantes como o sal, surgem como alternativa mais barata e segura às baterias de lítio. Seu impacto mais profundo para a indústria química não está apenas na mobilidade elétrica, mas na reconfiguração do acesso à energia.
Para fábricas de tintas, resinas, fertilizantes, papel e mineração, energia deixou de ser apenas um custo operacional e passou a ser um fator estratégico de continuidade. O armazenamento energético mais barato e seguro permite plantas industriais parcialmente autônomas, integração real com geração solar e/ou eólica e redução de risco energético em regiões remotas. No agronegócio, baterias de sódio podem viabilizar fertirrigação, mistura e bombeamento fora da rede. Na mineração, permitem a eletrificação de operações remotas. Do ponto de vista de governança e sustentabilidade, reduzem a dependência de lítio, um insumo com riscos geopolíticos e ambientais crescentes.

2. Programação generativa: o novo laboratório invisível
Ferramentas de programação baseadas em inteligência artificial estão revolucionando a forma como produzimos software. Para a indústria química, isso equivale ao surgimento de um laboratório digital paralelo, capaz de acelerar decisões técnicas, reduzir custos e preservar conhecimento.
As aplicações diretas incluem geração e otimização de formulações de tintas e revestimentos, simulação do impacto da substituição de matérias-primas, automação de experimentos estatísticos, análise reológica e criação automática de fichas técnicas, Ficha com Dados de Segurança e dossiês regulatórios.
Em resinas e emulsões, a inteligência artificial já permite prever propriedades como Temperatura de Transição Vítrea – Tg, Temperatura Mínima de Formação de Filme – MFFT e Composto Orgânico Volátil – VOC antes mesmo do primeiro teste físico. No agronegócio, otimiza blends de fertilizantes e adjuvantes. Em governança, automatiza compliance e rastreabilidade técnica. A indústria que dominar programação generativa não será apenas mais rápida, será estruturalmente mais inteligente.

3. Energia nuclear de nova geração: descarbonização estrutural
Reatores nucleares de nova geração, menores, modulares e mais seguros, reposicionam a energia nuclear como vetor de estabilidade energética. Para setores eletrointensivos como química pesada, papel e celulose e mineração, isso significa energia contínua, previsível e de baixa emissão.
Embora ainda distante do chão de fábrica na maioria dos países, essa tecnologia aponta para um futuro no qual processos químicos de alta demanda térmica sejam eletrificados, emissões de escopo 2 sejam drasticamente reduzidas e clusters industriais tenham fornecimento energético estável por décadas. Não se trata de uma solução imediata, mas de uma decisão estratégica de longo prazo para países e cadeias produtivas inteiras.

4. Companheiros de IA: conhecimento como ativo vivo
Chatbots avançados estão sendo usados como companheiros digitais. No ambiente industrial, o valor real está na criação de assistentes técnicos internos, treinados com o conhecimento da própria empresa.
Esses sistemas podem apoiar formulação, treinamento de operadores, consulta a normas e procedimentos e preservação do conhecimento tácito de equipes experientes. O risco existe, especialmente a dependência excessiva e decisões não auditáveis, o que torna a governança da inteligência artificial indispensável. Quando bem implementados, esses sistemas transformam conhecimento em um ativo vivo, acessível e escalável.

5. Edição genética por base: a nova fronteira da microbiologia industrial
A edição genética por base, uma evolução do CRISPR (Repetições Palindrômicas Curtas Agrupadas e Regularmente Interespaçadas), permite corrigir erros específicos no DNA com altíssima precisão. Seu impacto industrial vai muito além da medicina e se manifesta na engenharia de microrganismos.
As aplicações incluem microrganismos mais eficientes para produção de enzimas, bioinsumos agrícolas mais estáveis, bactérias adaptadas para biolixiviação na mineração e processos de biorremediação de resíduos químicos.
A indústria química caminha rapidamente para integrar a biotecnologia como parte central da inovação, e não como um nicho isolado.
6. Ressurreição genética: bioeconomia aplicada
A recuperação de genes ancestrais ou extintos abre novas possibilidades para a criação de enzimas mais resistentes a pH, temperatura e solventes, o aumento da diversidade genética em cepas industriais e soluções concretas para conservação ambiental e sustentabilidade.
No setor de papel e celulose, isso pode significar enzimas mais eficientes no branqueamento. Na mineração, bactérias seletivas para extração. Na indústria química, novos catalisadores biológicos. A chamada ressurreição genética não trata de nostalgia biológica, mas de ampliar o repertório tecnológico da vida.

7. Interpretabilidade mecanicista: confiança em IA para setores regulados
Modelos de inteligência artificial são poderosos, mas opacos. A interpretabilidade mecanicista busca explicar por que um modelo tomou determinada decisão.
Para a indústria química, altamente regulada, isso é decisivo. Não basta que a inteligência artificial recomende uma formulação, é preciso compreender os critérios técnicos por trás dessa decisão.
Essa abordagem viabiliza auditoria de modelos, aceitação regulatória, uso seguro de IA em P&D e qualidade e uma governança técnica robusta. Sem interpretabilidade, a inteligência artificial não escala em ambientes industriais críticos.

8. Estações espaciais comerciais: P&D além da gravidade
Embora pareça distante, o ambiente de microgravidade abre novas possibilidades para estudos de formação de filme em tintas, morfologia de polímeros e resinas e crescimento microbiológico controlado.
Historicamente, materiais desenvolvidos para o espaço retornam à Terra como inovações de alto valor. A indústria química mais avançada já observa esse ambiente como um laboratório extremo de pesquisa e desenvolvimento.

9. Classificação genética: método, não destino
A classificação genética de embriões humanos gera controvérsia ética. No entanto, o método estatístico-genético por trás dessa tecnologia é extremamente relevante para microbiologia industrial e agronegócio.
As aplicações incluem seleção de cepas mais produtivas, escolha de microrganismos com maior eficiência metabólica e otimização de biofertilizantes e bioadjuvantes. Nesse contexto, a tecnologia não escolhe pessoas, escolhe desempenho biológico.

10. Data centers de IA em hiperescala: a infraestrutura invisível
Nada disso existe sem infraestrutura digital. Data centers de inteligência artificial em hiperescala são a base de digital twins industriais (gêmeo digital), simulação massiva de formulações, modelagem de cadeias de suprimentos e análise ESG em tempo real.
O custo energético é elevado, mas o custo de não ter acesso a essa capacidade computacional é ainda maior: perder competitividade estrutural.

A Química do Futuro já começou, não será definida por uma única tecnologia, mas pela capacidade de integração. Energia, inteligência artificial, biotecnologia e governança caminham juntas.
Empresas químicas que enxergarem essas tecnologias apenas como tendências perderão tempo. As que as tratarem como ferramentas estratégicas, alinhadas à sustentabilidade, eficiência e inovação, construirão vantagem competitiva real.
Na W2S Consultoria, acreditamos que o futuro não se prevê, se constrói, com método, ciência, governança e visão sistêmica. E a química continuará sendo protagonista.
Se você leu até aqui e gostou desse assunto, conecte-se com a W2S em todos os nossos canais de comunicação para não perder nenhum assunto sobre Inovação, Governança e Tecnologia. Até a próxima!
Fonte: 10 BreakthroughTechnologies
MIT Technology Review, janeiro de 2026.
